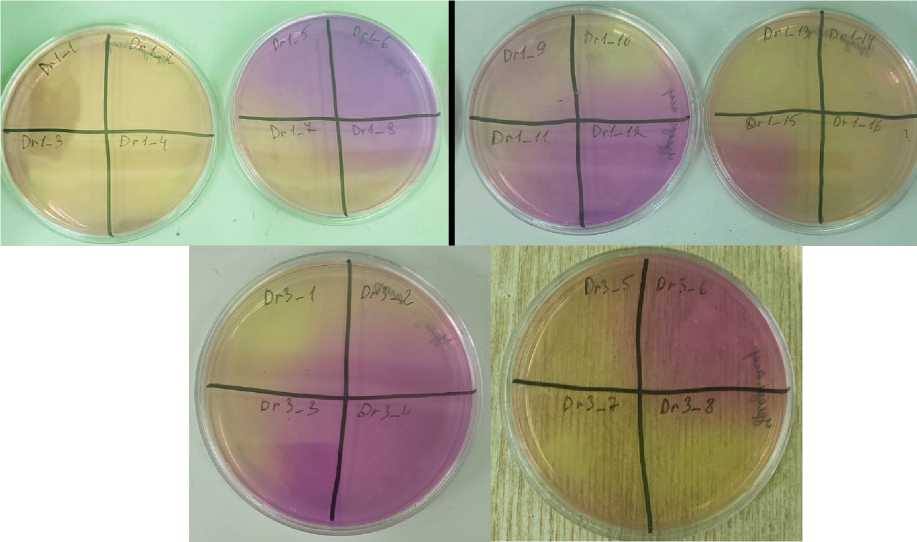
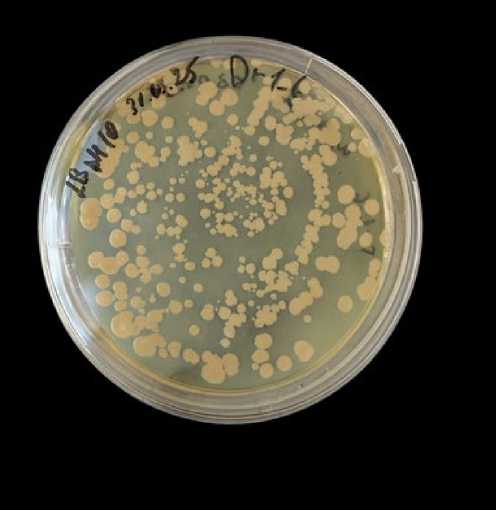

Микроорганизмы из древних уникальных структур: физиология, генетика, перспективы применения
Автор: Мазанко Мария Сергеевна, Празднова Евгения Валерьевна, Дёмин Константин Алексеевич, Никора Надежда Игоревна, Косых Алексей Олегович, Рыженкова Дарья Юрьевна, Сытик Валерия Сергеевна, Ельшаева Анастасия Михайловна, Вдовченков Евгений Викторович, Панченко Вадим Владимирович, Аллилуева Екатерина Владиславовна, Арамова Ольга Юрьевна, Корниенко Игорь Валерьевич, Щеглова Екатерина Сергеевна, Баженов Сергей Владимирович, Березов Родион Вячеславович, Манухов Илья Владимирович, Рахмани Хамид, Бахари Аббас, Чистяков Владимир Анатольевич, Кирсанова Татьяна Александровна
Журнал: Строительство уникальных зданий и сооружений @unistroy
Статья в выпуске: 5 (119), 2025 года.
Бесплатный доступ
Биобетон — это материал, который включает в себя определенные виды бактерий, а также несколько дополнительных компонентов, помимо обнаруженных. В обычном бетоне. Благодаря микробиологически индуцированному осаждению карбоната кальция (MICP), он способен предотвращать распространение микротрещин и герметизировать их. Используемые штаммы бактерий должны оставаться жизнеспособными в суровых условиях бетонирования, которые включают высокий pH, низкое содержание влаги, высокую плотность и повышенную температуру во время твердения. Было высказано предположение, что бактерии, способные выживать веками в древних строительных материалах, могут обладать свойствами, выгодными для применения в биобетоне. В этом исследовании жизнеспособные бактериальные споры были выделены из фрагментов древнего раствора, собранного из руин древнего города Херсонеса Таврического. Это место, уникальный памятник греческой архитектуры, существовавший до XV века н.э., расположено в районе современного Севастополя (Россия). Выделенные штаммы были оценены на их способность расти при pH 10, продуцировать уреазу, осаждать карбонат кальция и выдерживать цикл обработки бетона. Было проведено геномное секвенирование трех выбранных перспективных алкалофильных штаммов. Один из них был идентифицирован как потенциальный представитель ранее неописанного вида, Sutcliffiella sp., а два других были идентифицированы как Cytobacillus horneckiae (все принадлежат к семейству Bacillaceae). Геномный анализ выявил набор генов, связанных с производством карбонатных ионов и устойчивостью к щелочной среде.
Древние строительные растворы, Таврический Херсонес, Бактерии, Уреаза, Самовосстановление бетона, Карбонат кальция, Геномный анализ
Короткий адрес: https://sciup.org/143185210
IDR: 143185210 | DOI: 10.4123/CUBS.119.4
Microorganisms from ancient unique structures: physiology, genetics, application prospects
Bioconcrete is a material that incorporates specific bacterial species along with several additional components beyond those found in conventional concrete. Due to microbially induced calcium carbonate precipitation (MICP), it has the ability to prevent the propagation of microcracks and to seal them. The bacterial strains employed must remain viable under the harsh conditions of concrete formation, which include high pH, low moisture content, high density, and elevated temperature during curing. It has been hypothesized that bacteria capable of surviving for centuries within ancient construction materials may possess properties advantageous for bioconcrete applications. In this study, viable bacterial spores were isolated from fragments of ancient mortar collected from the ruins of the ancient city of Chersonesus Taurica. This site, a unique monument of Greek architecture that existed until the 15th century AD, is located in the area of modern Sevastopol (Russia). The isolated strains were evaluated for their ability to grow at pH 10, to produce urease, to precipitate calcium carbonate, and to withstand the concrete processing cycle. Genomic sequencing was performed for three selected promising alkalophilic strains. One of them was identified as a potential representative of a previously undescribed species, Sutcliffiella sp., while the other two were identified as Cytobacillus horneckiae (all belonging to the family Bacillaceae). Genomic analysis revealed a set of genes associated with carbonate ion production and resistance to alkaline environments.
Текст научной статьи Микроорганизмы из древних уникальных структур: физиология, генетика, перспективы применения
Концепция самовосстанавливающегося биобетона основана на использовании микробно-индуцированного осаждения карбоната кальция (Microbial-Induced Calcite Precipitation или MICP), при котором специально отобранные микроорганизмы способствуют образованию кристаллов CaCO 3 , заполняющих трещины в бетонной матрице. Этот процесс имитирует естественные механизмы биоминерализации и может активироваться при появлении трещин без вмешательства человека [1]–[3].
Основные требования к бактериям для биобетона включают способность к образованию эндоспор для выживания в экстремальных условиях, устойчивость к высокому pH (12-13) бетонной среды, способность к осаждению карбоната кальция и сопротивляемость механическим напряжениям во время смешивания бетона. Большинство исследований сосредоточено на использовании бактерий рода Bacillus из-за их способности образовывать споры, сохраняющие устойчивость к неблагоприятным условиям на протяжении многих лет [4]– [6]. Применение уреолитических бактерий, таких как Sporosarcina pasteurii и различные виды Bacillus , показало высокую эффективность в заживлении трещин [7], [8]. Эти бактерии катализируют гидролиз мочевины с образованием аммиака и углекислого газа, что приводит к повышению pH и осаждению CaCO 3 в присутствии ионов кальция [9], [10]. На сегодняшний день накоплено немало данных, свидетельствующих о положительном влиянии бактерий на прочностные характеристики биобетона за счет MICP. Тем не менее, существуют и аргументы, опровергающие опосредованный живыми бактериями вклад MICP в прочность бетона [11], [12].
В первую очередь, эффективность конкретных вариантов технологий биобетона определяется выживаемостью бактерий в среде бетона. Высокая щелочность (pH ≈ 13), повышение температуры во время гидратации цемента (до 70°C), механические напряжения при смешивании и ограничение размеров пор с течением времени создают экстремальные условия для микроорганизмов. Ivaškė и соавторы анализировали жизнеспособность инкапсулированных в альгинат кальция бактерий Bacillus pseudofirmus, Bacillus cohnii и Bacillus halodurans после помещения в цементный раствор [13]. Было показано, что бактерии разных видов имеют разную выживаемость и теряют ее с разной скоростью, однако к исходу 2-3 недели, процент жизнеспособных спор практически перестает меняться и сохраняется в пределах 2 - 6% по крайней мере до конца 8 недели. Таким образом, выживать в среде бетона могут только крайне устойчивые алкалофильные бактерии.
Анализ бактерий, выделяемых из бетонных конструкций, показал, что большинство из них относятся к филумам Actinobacteria, Proteobacteria и Firmicutes, с преобладанием родов
Arthrobacter , Bacillus и Paenibacillus . Интересно отметить, что спорообразующие Firmicutes ( Bacillus и Clostridium spp.) составляют немалую долю в микробном сообществе бетона, что подтверждает их естественную адаптацию к среде бетона [14]. Такие исследования в основном проводятся на современных конструкциях, либо на изготовленных в лаборатории образцах [14– 16]. Особый интерес представляют бактерии, выделенные из древних строительных материалов, т.к. некоторые древние сооружения обладают удивительными прочностными характеристиками, благодаря которым памятники архитектуры сохраняются многие сотни и даже тысячи лет. Вполне возможно, что определенную роль в сохранении прочности играют бактерии, вырабатывающие карбонат кальция. Исследования микробиома исторических памятников показали присутствие специализированных микробных сообществ, адаптированных к экстремальным условиям щелочной, соленой и олиготрофной среды [17–19]. Тем не менее, исследования микробиома древних строительных материалов все еще достаточно ограниченны и сосредоточены в основном на деградирующей роли бактерий для памятников архитектуры [18], [20], [21].
Создание нано- и микроразмерных неорганических покрытий является одним из наиболее перспективных способов защиты объектов культурного наследия из известняка и мрамора. Лабораторное тестирование стимулирования биогенного минералообразования на поверхности образцов известняковой кладки из средневекового пещерного города на плато Эски-Кермен (Крым, Россия) показывают перспективность применения этих покрытий для консервации и реставрации известняковых кладок [22], [23].
Настоящее исследование было сосредоточено на выделении и характеристике жизнеспособных бактериальных спор из образцов древнего кладочного раствора из построек Херсонеса Таврического (Севастополь, Россия), уникального памятника греческой архитектуры, основанного в V веке до н.э. и просуществовавшего до XV века н.э. Было выдвинуто предположение, что длительная экспозиция древнего кладочного раствора в естественных условиях могла способствовать селекции бактерий с особыми свойствами адаптации к щелочной среде и способностью к биоминерализации.
Для оценки перспектив практического использования выделенных культур изучалась их способность расти при pH 10, продуцировать уреазу, образовывать кристаллы карбоната кальция и переживать условия процессинга современного бетонного раствора.
2 Materials and Methods
2.1 Sampling of ancient solution
2.2 Isolation of viable ureolytic alkalophilic bacteria capable of precipitating CaCO3 from ancient solution samples
2.3 Assessment of the survival of bacterial strains in concrete processing conditions
Сбор образцов проводился на раскопках древних сооружений Херсонеса Таврического– эталонного памятника античного и средневекового времени, сохранившегося на территории современного Севастополя (Россия).
Фрагменты и куски раствора были взяты из материалов раскопок в слоях поздней античности и раннего средневековья Херсонеса. Образец №1 представлял собой кладочный раствор из древнего водохранилища. Комплекс городского водохранилища с прилегающими постройками является одним из самых значительных памятников архитектуры, открытых на территории Херсонеса. Центральным сооружением архитектурного ансамбля является прямоугольная цистерна, стены которой сложены на известковом растворе с добавлением песка и дробленой керамики (пуццолановой добавки из тесаных известняковых блоков). Исходя из анализа археологического материала, функционирование комплекса водохранилища относится к III - IX вв. н.э. [24]. Образец №3 представлял собой цемент с керамикой (IV-X век н.э.) из ванны для засолки рыбы (рыбозасолочной цистерны). Большинство цистерн вырублены в скале и достроены бутовым или грубо отесанным камнем, стенки оштукатурены прочной цемянкой розового цвета [25]. Отбор образцов производился из облицовки стен цистерн 89 и 90, расположенных на северном берегу Херсонеса. Археологические образцы были взяты в соответствии со стандартной процедурой отбора. После сбора образцы были упакованы в стерильные контейнеры для предотвращения их загрязнения и разрушения, контейнеры были промаркированы уникальными идентификационными номерами и отправлены в лабораторию для дальнейшего изучения.
В первую очередь проводилась тщательная стерилизация поверхности образцов раствора для исключения попадания посторонней микрофлоры. Каждый образец облучался ультрафиолетом (мощность лампы - 30 Вт) по 30 минут с каждой стороны, в общей сложности 3 часа. Затем образцы заворачивались в несколько слоёв стерильной фольги, дробились молотком и разворачивались в стерильном ламинарном боксе. В фольге находились агрегаты древних строительных материалов, крошка и пыль. Крупные фрагменты отбирались стерильным пинцетом, а пыль набиралась на стерильный шпатель. Порции массой 0.1 г равномерно распределялись по поверхности агаризованной среды на чашке Петри.
В качестве питательной среды для выделения бактерий использовалась универсальная питательная среда LB (Luria-Bertani) [26] с добавлением NaOH до pH 10. Чашки инкубировались при комнатной температуре, учет выросших колоний проводился через 18 часов, через сутки и через 3 и 5 суток.
Выросшие на чашках колонии жизнеспособных бактерий отбирались петлей и переносились на следующие среды: LB (рН 10), для выявления свойств алкалофильности; уреазный агар по Кристенсену для обнаружения активности уреазы, LB с внесением 10 г/л лактата кальция для определения способности осаждать кристаллы СаСО 3 . Результаты на уреазном агаре и LB pH10 снимались (учитывались?) через 18 часов, результаты на среде с лактатом кальция учитывались через 48 часов. На среде с рН10 регистрировался рост колоний бактерий, на уреазном агаре наблюдалось ярко-малиновое окрашивание вокруг колоний, свидетельствующее об уреазной активности. Колонии на среде с лактатом кальция микроскопировались с целью выявить кристаллы карбоната кальция. Штаммы, удовлетворяющие требованиям, переносились на твердую LB pH10, проверялись на чистоту методом истощающего штриха и далее помещались в коллекцию.
На основе штаммов, выделенных из образцов древнего кладочного раствора, которые обладали наиболее перспективными свойствами (алкалофильность, уреазная активность, способность образовывать карбонат кальция из лактата кальция) и стабильно росли в лабораторных условиях, были изготовлены бактериальные препараты. Предварительное наращивание биомассы бактерий для препарата проводилось на чашках с твердой питательной средой LB (Luria-Bertani) при комнатной температуре в течение двух суток. Препараты готовились на основе твердофазного культивирования, в качестве субстрата использовались гидратированные соевые бобы [27]. Титр живых бактерий, подготовленных для внесения в бетон, составлял ~ 6×108 КОЕ/г.
Приготовление бетонных кубиков проводилось путем смешивания 100 г цемента, 300 г песка, 150 мл воды и 0.2 г сухого бактериального препарата. Компоненты тщательно перемешивались, заливались в формы. Формы уплотнялись постукиванием и помещались на 30°С. После созревания бетонных кубиков в течение 28 дней, проводился высев жизнеспособных спор бактерий по методике, описанной в п. 2.2, на чашки с питательной средой LB с рН 10. В методику была внесена небольшая модификация, заключающаяся в том, что 1 грамм стерильно измельченного бетона помещался на чашки с питательной средой не напрямую (т.к. частицы бетона мешают корректному учету бактерий), а предварительно суспендировался в 2 мл физ. раствора. Затем суспензия высевалась на чашки с питательной средой LB рН 10. Учет выросших колоний проводился на 5 день после посева.
2.4 Genome-wide sequencing of isolated bacterial strains
Для секвенирования из чистых культур бактерий выделялась геномная ДНК с помощью метода [28]. Качество выделения ДНК оценивалось с помощью электрофореза в 1% агарозном геле. Концентрация ДНК определялась спектрофотометрически на приборе NanoDrop 1000 (Thermo Scientific, США).
Подготовка библиотек проводилась по стандартной методике для полногеномного секвенирования «Neb Next Ultra2» DNA Library Prep Kit for Illumina.
Секвенирование проводилось на Illumina MiSeq (длина прочтений - 250 п.о. с двух сторон фрагментов) с использованием реактивов MiSeq Reagent Kit v2 (500 cycles). Файлы FASTQ были получены с помощью ПО bcl2fastq v2.17.1.14 Conversion Software (Illumina).
2.5 Genomic data collection and analysis
Сборка геномов проводилась согласно следующему алгоритму: контроль качества прочтений с помощью FastQC v0.12.0 [29], тримминг адаптеров и низкокачественных оснований в Trimmomatic v0.39 [30], de novo сборка генома в SPAdes v4.1.0 [31] и таксономическая идентификация по базе GTDB [32] с использованием стандартного рабочего процесса GTDB-Tk v2.4.0 с референс-пакетом GTDB R226 [33]. Функциональная аннотация выполнялась с помощью DIAMOND v2.1.9 [34] в режиме protein–protein (blastp) против пользовательской базы белков, сформированной из базы данных AnnoTree [35], а также с помощью программ METABOLIC [36] и Prokka [37] с параметрами по умолчанию.
-
3 Results and discussion
3.1 Isolation and analysis of viable bacteria from samples of ancient masonry mortar
Был проведен сбор образцов кладочного раствора на раскопках древних сооружений Херсонеса Таврического, а затем был проведен анализ двух образцов. Жизнеспособные споры, заключенные в собранных образцах, активировались и высевались на питательные среды. Отбор колоний различных микроорганизмов для последующего анализа проводился, основываясь на морфологических отличиях. Обсемененность образца 1 (цементный раствор из древнего водохранилища) составила 1.6±0,3×103 КОЕ, обсемененность образца 3 (ванна для засолки рыбы) составила 5.4±0,4×102 КОЕ. Из образца 1 были выделены 16 штаммов бактерий (Dr1_1 – Dr1_16), из образца 3 были выделены 8 штаммов (Dr3_1 – Dr3_8). На рисунке 1 представлено фото чашки Петри с выросшими колониями.

Fig. 1 – Growth of colonies of viable bacteria from the Dr1 sample. The image was made by the author of the article
Рис. 1 - Рост колоний жизнеспособных бактерий из образца Dr1. Изображение выполнено автором статьи
Все изолированные штаммы исследовались на алкалофильность, уреазную активность и способность образовывать карбонат кальция из лактата кальция. Интересно, что, хотя большинство выделенных штаммов не вырабатывали уреазу, некоторые штаммы, наоборот, обладали ярко выраженной уреазной активностью (рис. 2).
Fig. 2 – Urease activity of strains of viable bacteria isolated from samples of ancient building materials (strain number is indicated on the plate). The image was made by the author of the article Рис. 2 - Уреазная активность штаммов жизнеспособных бактерий, выделенных из образцов древних строительных материалов (номер штамма указан на чашке). Изображение выполнено автором статьи
Можно предположить, что именно наличие высокой уреазной активности обеспечило сохранность археологических образцов за тысячелетний период. Свойства изолятов представлены в таблице 1.
Table 1 – Properties of viable strains isolated from samples of ancient building materials
Таблица 1 - Свойства жизнеспособных штаммов, выделенных из образцов древних строительных материалов
|
Код штамма |
Рост при рН10 |
Образование СаСО 3 из лактата кальция |
Уреазная активность |
|
Образец 1 |
|||
|
Dr1_1 |
+++ |
- |
- |
|
Dr1_2 |
+++ |
- |
- |
|
Dr1_3 |
+++ |
- |
- |
|
Dr1_4 |
++ |
- |
- |
|
Dr1_5 |
+++ |
- |
+ |
|
Dr1_6 |
+++ |
- |
+++ |
|
Dr1_7 |
+++ |
- |
- |
|
Dr1_8 |
+++ |
- |
- |
|
Dr1_9 |
+++ |
- |
+ |
|
Dr1_10 |
+++ |
- |
- |
|
Dr1_11 |
+++ |
- |
- |
|
Dr1_12 |
- |
- |
+++ |
|
Dr1_13 |
- |
- |
- |
|
Dr1_14 |
++ |
- |
- |
|
Dr1_15 |
+++ |
- |
++ |
|
Dr1_16 |
- |
- |
- |
|
Образец 3 |
|||
|
Dr3_1 |
+ |
+ |
- |
|
Dr3_2 |
+++ |
- |
- |
|
Dr3_3 |
+++ |
- |
- |
|
Dr3_4 |
+++ |
+++ |
+++ |
|
Dr3_5 |
++ |
- |
- |
|
Dr3_6 |
++ |
+ |
+ |
|
Dr3_7 |
+ |
- |
- |
|
Dr3_8 |
+++ |
- |
- |
Интенсивность роста на щелочной среде, образования кристаллов СаСО 3 , окрашивания уреазного агара оценивали визуально. «-» - отсутствие изучаемого признака. «+» - слабая интенсивность роста (образования кристаллов СаСО 3 , окрашивания уреазного агара); «++» -средняя интенсивность роста (образования кристаллов СаСО 3 , окрашивания уреазного агара); «+++» - высокая интенсивность роста (образования кристаллов СаСО 3 , окрашивания уреазного агара).
Среди выделенных штаммов было мало изолятов, обладающих способностью разлагать лактат кальция с образованием нерастворимой соли. Единственный штамм Dr3_4 образовывал крупные кристаллы (рис. 3), ещё 2 были способны образовать только мелкие разрозненные кристаллы, остальные не усваивали лактат из среды. Практически все бактерии были способны расти в алкалофильных условиях. К сожалению, рост большинства штаммов оказался нестабильным в лабораторных условиях.

Fig. 3 – Calcium carbonate crystals formed in the biomass of the colony of strain Dr3_4. The image was made by the author of the article
Рис. 3 - Кристаллы карбоната кальция, образовавшиеся в биомассе колонии штамма Dr3_4. Изображение выполнено автором статьи
Для дальнейших исследований были отобраны штаммы, стабильно растущие в лабораторных условиях – Dr1_2, Dr1_6, и Dr3_4. Все они обладали способностью расти в щелочных условиях, штаммы Dr1_6 и Dr3_4 обладали высокой уреазной активностью, а Dr3_4, помимо этого, продемонстрировал также высокую выработку карбоната кальция из лактата кальция.
Уреолитические виды бактерий, устойчивые к щелочам, наиболее часто используются для самовосстанавливающихся цементных материалов [38], [39]. Благодаря уреазной активности, они могут разлагать мочевину (CO(NH 2 ) 2 ) на аммиак (NH 3 ) /аммоний (NH 4 +) и карбонат-ионы (CO 3 2-). Осаждение карбоната кальция бактериями может быть обусловлено как действием клеточной стенки, так и механизмом карбоангидразы [6]. Отрицательно заряженная клеточная стенка может сорбировать положительно заряженные ионы кальция, которые затем соединяются с карбонат-ионом, образуя CaCO 3 . Механизм действия карбоангидразы при осаждении CaCO 3 включает катализ гидратации CO 2 , что приводит к образованию ионов бикарбоната, которые могут реагировать с ионами кальция с образованием твердого CaCO 3 . Интересно, что среди выделенных уреолитических штаммов (Dr1_6 и Dr3_4) только один обладал способностью формировать кристаллы карбоната кальция, что может быть обусловлено особенностями регуляции уреазы [10]. Hammes и соавторы [40] показали, что кальцификация в процессе уреолитического микробного осаждения карбоната была штаммоспецифичной, и эта специфичность была обусловлена главным образом различиями в экспрессии уреазы при разных концентрациях кальция.
Объекты окружающей среды, особенно с неблагоприятными условиями, могут быть хорошим источником перспективных штаммов бактерий для инженерного применения. Например, в прибрежной зоне штата Тамил Наду (Индия) из образцов песчаника и морских отложений были выделены штаммы, обладающие высокой уреазной и кальцификационной активностью, потенциально применимые для укрепления береговой линии за счет цементации пляжного песка [41], [42]. Gandhi и соавторы [43] использовали штаммы бактерий, выделенных со свалок, для создания биокирпичей с применением MICP. Так, с муниципального полигона твердых отходов Пирана (Индия) были изолированы восемь штаммов, два из которых ( Bacillus altitudinis PN3 и Bacillus thaonhiensis PN7) продемонстрировали в 2–2.5 раза более высокую активность уреазы и карбоангидразы, лучшую адаптируемость к изменениям pH и температуры, а также улучшенные биоминерализующие свойства. Спорообразующие бациллы для самовосстановления бетона были выделены Otiniano и соавторами из почв известняковых шахт Симбал, Трухильо, Ла-Либертад, Перу [44]. Источником бактериального сообщества внутри бетона могут выступать его компоненты, такие как крупный гравий, песок и т.д. [14].
3.2 Survival of bacteria from ancient structures in the conditions of concrete maturation
Из исследованных бактерий наилучшую выживаемость в условиях созревания бетона показали штаммы Dr1_6 и Dr3_4, немного хуже выживал штамм Dr1_2. Титр бактерий Dr1_6 составлял 4.2×103 на 1 грамм бетона, Dr3_4 - 1.1×103 на 1 грамм бетона, Dr1_2 - 2.1×102 на 1 грамм бетона. На рисунке 4 представлено фото чашки Петри с выросшими колониями микроорганизмов, пережившими процесс созревания бетона.
Fig. 4 – Bacteria of the Dr1_6 strain, re-seeded from a concrete sample. The image was made by the author of the article
Рис. 4 - Бактерии штамма Dr1_6, повторно высеянные из образца бетона. Изображение выполнено автором статьи
Выживание бактерий в бетоне является проблемой, несмотря на способность спор противостоять механическим и химическим воздействиям и длительный срок их жизни. Основными препятствиями к выживанию являются высокая щелочность бетона (pH может составлять около 13 после гидратации обычного портландцемента) и относительно небольшой размер пор из-за гидратации цемента [45]. Jonkers и соавт. показали, что диаметр пор в образцах цемента, выдержанных в течение 3 и 7 дней, составлял 0.1–1 мкм, а спустя 28 дней выдержки он был уже 0.01–0.1 мкм, что меньше среднего диаметра бактериальной споры [46]. Кроме того, споры должны выдерживать высокое напряжение сдвига во время смешивания, высокие температуры во время гидратации цемента и напряжение дегидратации после затвердевания. Можно предполагать, что количество сохраняющихся жизнеспособных спор бактерий будет достаточным для того, чтобы при растрескивании свежего биобетона споры были активированы попавшими (даже небольшими) количествами влаги и питательных веществ и запустили процесс самовосстановления бетона.
3.3 Identification and genomic characterization of bacterial strains isolated from ancient building materials
Геномы штаммов, обладающих наиболее перспективными свойствами (алкалофильность, уреазная активность, способность образовывать карбонат кальция из лактата кальция), а также показавших хорошую повторную выживаемость в бетоне, были секвенированы. Полногеномный анализ с помощью базы GTDB позволил идентифицировать эти штаммы как Sutcliffiella sp. и C. horneckiae (Таблица 2).
Table 2 – Results of genomic identification of strains isolated from an ancient solution Таблица 2 - Результаты геномной идентификации выделенных из древнего раствора штаммов
|
Номер |
Род и вид |
Ближайший геномный референс |
Идентичность с ближайшим геномом |
Относительная эволюционная дивергенция |
|
Dr1_2 |
Sutcliffiella sp. |
N/A |
N/A |
0.96268 |
|
Dr1_6 |
C. horneckiae |
GCF_002835 735.1 |
99.3 |
- |
|
Dr3_4 |
C. horneckiae |
GCF_002835 735.1 |
99.3 |
- |
Анализ результатов таксономической классификации показал, что изолят Dr1_2 представляет собой новый, не описанный ранее вид в составе рода Sutcliffiella . Геном не имел достаточного сходства с существующими референсными геномами GTDB для присвоения видового статуса, что подтверждается отсутствием средней нуклеотидной идентичности (closest genome ANI) к ближайшему типовому штамму и невозможностью применения пороговых критериев видовой принадлежности. Филогенетическая классификация на основе размещения в дереве маркерных генов определила таксономическую принадлежность изолята только до родового уровня с высоким значением относительной эволюционной дивергенции (RED value = 0.96), что указывает на значительную генетическую обособленность от описанных представителей рода и подтверждает статус данного изолята как кандидата в новые виды, требующего дальнейшего исследования.
Также было обнаружено, что Sutcliffiella sp. имеет гены транспорта эктоина, обеспечивающего устойчивость к засолению и щелочным условиям.

Cytobacillus homeckiae
Fig. 5 – The results of the functional annotation of the studied bacterial strains
Рис. 5 - Результаты функциональной аннотации изученных штаммов бактерий
Cytobacillus является родом в семействе Bacillaceae, представители которого известны своей способностью выживать в экстремальных условиях и способствовать процессам осаждения карбоната кальция, опосредованных активностью уреазы или выработкой карбоангидразы. Хотя специальные исследования Cytobacillus в биобетоне отсутствуют, его принадлежность к семейству Bacillaceae предполагает, что он может иметь сходные применения. Исследования подтверждают успешное применение различных видов Bacillus для улучшения прочностных характеристик бетона и заживления трещин в нем [47].
Несомненным преимуществом обнаруженных в данном исследовании штаммов Cytobacillus является их способность выживать в щелочной среде. Как древние строительные материалы в момент создания, так и бетон имеют высокий уровень pH, и Cytobacillus , вероятно, адаптирован к этим условиям, что делает его потенциальным кандидатом для применения в самовосстанавливающемся бетоне. Подобно видам Bacillus , Cytobacillus также может образовывать спящие споры, которые могут выживать в экстремальных условиях и активироваться при возникновении благоприятных условий (например, влажности), обеспечивая долгосрочную функциональность в биобетоне. Таким образом, хотя прямых доказательств нет, характеристики Cytobacillus предполагают, что он может играть роль в микробном самовосстановлении бетона, особенно из-за его вероятных возможностей биоминерализации и устойчивости к окружающей среде [48].
Род Sutcliffiella относится к грамположительным палочковидным бактериям семейства Bacillaceae. Он был описан только в 2020 г., и в него вошел ряд видов бактерий, ранее относившихся к роду Bacillus [49]. Представители этого рода были обнаружены в различных экстремальных местообитаниях. Так, Bai и соавторы [50] сообщили о выделении штамма Sutcliffiella DG-18T из образцов пустынной почвы, отобранных в пустыне Кубуци во Внутренней Монголии, Китай. Он был способен расти при температуре 4–40 °C и pH 8.0–10.0. Термофильный штамм Sutcliffiella sp. BAT, способный расти при температуре 28–46 °С, был выделен Муратовой и соавторами из резервуара для испарения воды на батарее отопления. В его геноме были обнаружены плазмиды с генетическими детерминантами, кодирующими ряд ферментов и метаболитов, которые могут способствовать адаптации к экстремальным условиям путем активации процессов спорообразования и формирования биопленок [49].
Таким образом, выделенные в ходе данной работы штаммы способны переносить неблагоприятные условия, характерные для бетона (высокий рН и температура, низкое содержание питательных веществ), и могут служить перспективными добавками, повышающими прочностные характеристики самовосстанавливающихся строительных материалов.
-
4 Conclusion
Было установлено наличие жизнеспособных спор бактерий во фрагментах древнего строительного раствора археологического памятника Херсонес Таврический. Выделенные штаммы бактерий были идентифицированы как Sutcliffiella sp. и C. horneckiae , они обладают алкалофильностью, два из них - высокой уреазной активностью и один - способностью к образованию кристаллов карбоната кальция. Выделенный изолят Sutcliffiella представляет собой новый, не описанный ранее вид в составе рода. Показана способность клеток обнаруженных штаммов выживать в достаточном количестве при повторном процессе созревания бетона. За счет чего можно предположить, что изолированные штаммы могут служить основой для разработки перспективных биодобавок для самовосстанавливающегося биобетона. Проверка этого предположения станет предметом дальнейших исследований.
-
5 Acknowledgements
Авторы работы выражают благодарность профессору Е.И. Ватину за помощь в организации исследований.
-
6 Fundings
This research was supported by a grant from the Russian Science Foundation No. 24-44-20012, https://rscf.ru/en/project/24-44-20012/ .
-
7 Conflict of Interests
The authors declare no conflict of interest.


